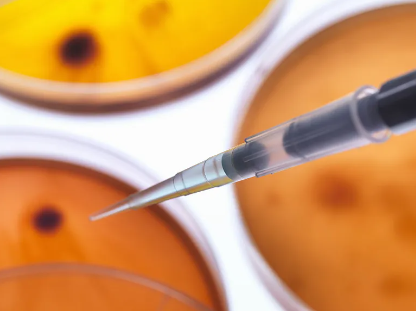
幹細胞治療幾個療程有效果？療程周期如何安排？

幹細胞治療幾個療程有效果?療程周期如何安排?
2024-10-16 17:46:56 來源: 小編 咨詢醫生
幹細胞治療作爲一種前沿的生物技術,近年來在醫學領域取得了顯著的成果。許多患者關心幹細胞治療的效果和療程周期,下面我們來詳細探讨這兩個問題。
首先,幹細胞治療幾個療程有效果?
幹細胞治療的效果因人而異,取決于患者的病情、體質以及治療方法的差異。一般來說,經過1-3個療程的治療,患者可以感受到一定的效果。以下是幾個療程的常見效果:
1.第一個療程:患者可能會感覺到疲勞感減輕,免疫力提高,身體逐漸恢複活力。
2.第二個療程:患者的病情可能會有所改善,例如疼痛減輕、傷口愈合速度加快等。
3.第三個療程:患者的身體狀況可能會有明顯改善,病情得到控制,生活質量提高。
需要注意的是,幹細胞治療并非一蹴而就的過程,患者需耐心等待療效的顯現,并在醫生的指導下進行後續治療。
接下來,我們來談談幹細胞治療的療程周期如何安排。
幹細胞治療的療程周期通常分爲以下幾個階段:
1.評估階段:在開始治療前,醫生會對患者進行詳細的評估,包括病情、體質、治療方案等,以制定個性化的治療方案。
2.準備階段:在治療前,患者需要做好充分的準備,如調整飲食、加強鍛煉等,以提高治療效果。
3.治療階段:根據患者的病情和體質,醫生會制定相應的治療周期。一般來說,每個療程的時間爲1-2個月,期間患者需要定期到醫院進行複查和評估。
4.觀察階段:治療結束後,患者需要定期到醫院進行複查,觀察病情的變化,以便及時調整治療方案。
5.維持階段:在病情穩定後,患者需要遵循醫生的建議,保持良好的生活習慣,定期進行體檢,以預防病情複發。
總之,幹細胞治療的效果和療程周期因人而異,患者需要在醫生的指導下進行個性化的治療。如果您對幹細胞治療感興趣,請務必選擇正規醫療機構進行咨詢和治療,以确保安全和療效。
-
上一頁: 膝蓋幹細胞療法真的有效嗎?患者評價如何?
-
下一頁: 造血幹細胞移植腫瘤治療成功案例有哪些?
- 2024-11-16幹細胞移植青光眼能治好嗎,效果如何
- 2024-07-17幹細胞能根治慢性腎髒病嗎,幹細胞修複腎功能的功效原理
- 2024-10-25幹細胞免疫療法銷售渠道有哪些?
- 2024-11-07NK幹細胞療法過程是怎樣的?如何提高NK幹細胞治療效果?
- 2024-10-24幹細胞治療偏癱效果好嗎?如何選擇最佳幹細胞治療偏癱方案?
- 2024-11-06幹細胞治療耳聾臨床效果與進展?
- 2024-10-04幹細胞治療疤痕效果怎樣,适用哪些疤痕
- 2024-07-24幹細胞治療半月闆損傷,幹細胞能修複半月闆嗎多少錢
- 2024-10-07南通幹細胞作用有哪些?與本地醫療機構有何合作?
- 2024-09-26廣州幹細胞儲存費用,附上機構價格明細
- 2024-09-07捐造血幹細胞的危害有哪些,捐贈造血幹細胞的利弊
- 2024-09-27廣州艾樂貝拉正規嗎
- 2024-10-07造血幹細胞在人體中如何分布?對健康有哪些影響?
- 2024-09-16幹細胞技術高度近視能恢複嗎
- 2024-08-22幹細胞移植的副作用,幹細胞移植利弊
- 2024-09-23幹細胞局部移植費用多少,收費明細一覽
- 2024-09-25幹細胞治療什麽疾病比較好,附治療疾病種類和效果
- 2024-09-05幹細胞填充全過程及注意事項
